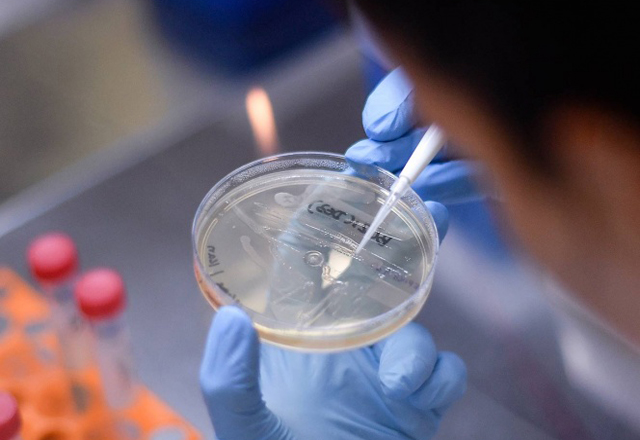

Destacado
Exhorta AMLO a capitalinos a actuar con responsabilidad ante fiestas decembrinas
En un mensaje a la nación, en especial a los habitantes de la Ciudad de México, el presidente Andrés Manuel López Obrador exhortó a que en las celebraciones navideñas se actué con responsabilid
leer másCaso Cienfuegos socava confianza bilateral, advierten en EU; urge revisar Iniciativa Mérida
Washington.— Revaluar la Iniciativa Mérida es una “necesidad urgente” para mejorar en la lucha conjunta de Estados Unidos y México contra el narcotráfico. Esa sentencia es la conclusión más
leer másPiden a extranjeros no arriesgarse a venir si no es esencial su viaje
En las últimas semanas ha resurgido el tema de la llegada a México de residentes de Texas sobre todo, a pesar de las restricciones que hay entre ambos gobiernos muchos quieren seguir visitando Matam
leer másDesinfectan el transporte sólo en las terminales oficiales
El trabajo de desinfectar las unidades del transporte sigue en marcha mientras no se acabe la pandemia. Ahora lo hacen de manera selectiva y en las terminales ya sea de camiones o taxis donde el perso
leer másCierran iglesias católicas del 10 al 13 de diciembre para cumplir con recomendaciones sanitarias
Las asociaciones religiosas no sólo han cumplido las recomendaciones del sector salud en el tema de la contingencia sanitaria, sino que además se han convertido en un importante soporte para las fam
leer másSe intensifica el arribo de paisanos en puente
Al acercarse la festividad decembrina y pese a las recomendaciones que se ha hecho a las personas para que de preferencia no viajen, en el puente internacional General Ignacio Zaragoza se registra ya
leer másSEP analiza regreso a clases presenciales en algunos estados: AMLO
El presidente Andrés Manuel López Obrador señaló que la Secretaría de Educación Pública (SEP) ya analiza con maestros el regreso presencial a clases en algunos estados del país, esto con el ob
leer másAún sin localizar a padres de 628 niños migrantes separados en la frontera de EU
San Diego— Una comisión designada por un tribunal sigue sin localizar a los padres de 628 menores migrantes que fueron separados en la frontera con México cuando comenzaba el gobierno del presiden
leer másPlan de distribución de vacuna de covid sufre ciberataque
BOSTON.- Investigadores de seguridad de IBM dijeron que detectaron intentos de ciberespionaje con correos electrónicos de phishing dirigido para tratar de recopilar información vital sobre la inicia
leer másEmpresarios esperan el arranque del puerto de Matamoros
Como una nueva alternativa para reactivar la economía, empresarios fronterizos urgen a los tres niveles de gobierno avanzar en la construcción del puerto de Matamoros, proyecto impulsado desde admin
leer más